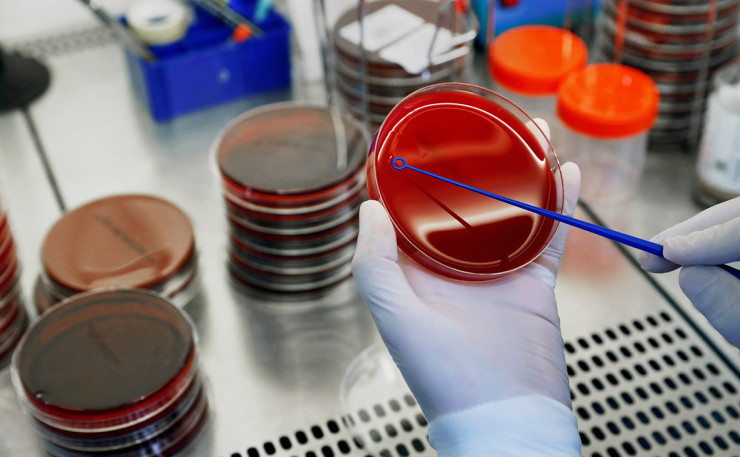

Еуропа елдерінде коронавирустың мутацияланған жаңа штамы тарай бастады. Зерттеу деректері бойынша, қыркүйекте мутацияланған вирус Швейцария, Ирландия мен Ұлыбританияда жаңа жағдайлардың 40-70 пайыз артуына әсер еткен. Инфекцияның жаңа мутацияланған түрі Норвегия, Латвия, Нидерланд пен Францияда тарай бастаған. Вирус не үшін мутацияланады және ол несімен қауіпті? Бұл туралы Tengrinews.kz тілшісінің материалында.
Вирус не үшін мутацияланады?
Коронавирустың мутациялануы негізгі екі ошағы бар - ухандық және еуропалық немесе италиялық. Бәрі ухандық түрінен басталған. Яғни Қытайдан Иранға, артынша Италияда тарап, шамамен ақпан айында вирус мутацияланды. Вирус мутацияланғанда аса қауіпті болмайды, бірақ оның адамнан адамға жұғу қабілеті 10 есе артады екен. Оның себебін медицина профессоры Алмаз Шарман былай деп түсіндіреді:
"Тірі қалу мақсатында вирус мутацияланып, тез жұғу қабілетіне ие болғанымен аса қауіпсіз болады. Адам вирус жұқтырып, ол организмде мутацияланғанын елестетіңіз. Ол адам вирустың екі түрін тасымалдаушы болады: бірі жұқтырушы болса, екіншісі қауіпті түрі. Сосын ол вирусты тағы екі адамға жұқтырады. Қауіпті вирусты жұқтырған адам үйіне барып, төсекке жатып, қайтыс болуы мүмкін. Ал вирустың қауіпсіз, бірақ адамға тарайтын түрін жұқтырған адам аман қалуы мүмкін. Ол адам сауық кешіне немесе жиынға барып ондаған адамға вирус жұқтыруы мүмкін. Осылайша вирус эволюцияға ұшырап, адамдар арасында тез тарау қабілетіне ие болады", - дейді профессор.
Яғни вирус тірі қалуы үшін "қожайынын" өлтіру ол үшін тиімсіз, себебі бұл жағдайда вирустың өзі де өліп қалады.
"Вирус - бізсіз, "қожайынсыз" ешкім емес. Ол адамсыз өмір сүре алмайды, себебі вирус - паразит. Сондықтан вирустың "қожайыны" үшін қауіпсіз, бірақ жұқтыру қабілетімен болғаны маңыздырақ. Сол жағдайда ол тірі қалып қана қоймай, адамдар арасында тез тарау қабілетіне ие болады", - деп түсіндірді профессор.
© Reuters
© Reuters
Мутацияланған вирустың тез тарайтыны туралы АҚШ-тың бас инфекционисі Энтони Фаучи де айтқан болатын.
"Бұған қатысты түрлі әңгіме айтылып жатыр, бірақ мен мутация вирустың тарауын тездетіп, оның адам ағзасындағы концентрациясын арттырады деп есептеймін", - деді сарапшы.
Коронавирустың жаңа штамдары туралы не белгілі?
Былтыр Қытайдың Ухан қаласында анықталған COVID-19-дың өзі де бұрыннан белгілі коронавирустың жаңа штамы. Алайда бұған дейін бірнеше елде коронавирустың аса қауіпті штамдары анықталған. Оның ішінде, Оңтүстік Корея, Норвегия, Вьетнам, Филиппин бар.
Биыл шілдеде Оңтүстік Кореяда коронавирустың жаңа штамы - GH анықталған. Ол COVID-19-дың басқа түрлеріне қарағанда тез әрі жылдам тарайды.
 © Reuters
© Reuters
Кореяның ауруларды бақылау және алдын алу орталығы (KCDC) коронавирус анықталған 526 науқастың вирус геномын жүйелеп, GH тобына жататын 333 адамды анықтаған.
ДДҰ басқаратын GISAID вирустар геномының мәліметтер базасына сәйкес, COVID-19 жеті штамға жіктеледі - S, V, L, G, GH, GR және O. Оңтүстік Кореяда L-ден басқасының бәрі табылған. Бастапқыда елде Қытайдан тараған S штамы анықталып, сосын ол V штамына мутацияланған. Одан бөлек, Оңтүстік Кореяда сәуір мен мамыр айларында G, GR штамы тараған. Олар шетелден келген адамдардан анықталған.
S штамының мутациясы болып саналатын GH штамы коронавирустың басқа түрлеріне қарағанда алты есе тез тарайды. Одан бөлек, биыл тамыз айында Оңтүстік Кореяда Пәкістаннан және Өзбекстаннан келген екі адамнан вирустың мутацияланған түрі анықталған.
Қазақстан жаңалықтары. Соңғы жаңалықтар. Telegram желісінде бізге жазыл!



